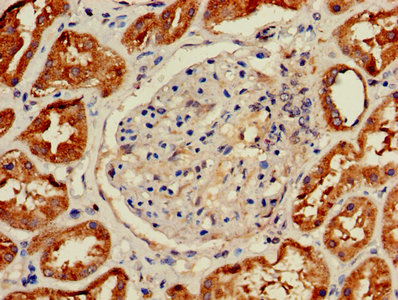

HIST2H2AC Antibody
-
中文名稱:HIST2H2AC兔多克隆抗體
-
貨號:CSB-PA010445LA01HU
-
規格:¥440
-
圖片:
-
其他:
產品詳情
-
產品名稱:Rabbit anti-Homo sapiens (Human) HIST2H2AC Polyclonal antibody
-
Uniprot No.:
-
基因名:
-
別名:HIST2H2AC antibody; H2AFQ antibody; Histone H2A type 2-C antibody; Histone H2A-GL101 antibody; Histone H2A/q antibody
-
宿主:Rabbit
-
反應種屬:Human
-
免疫原:Recombinant Human Histone H2A type 2-C protein (2-129AA)
-
免疫原種屬:Homo sapiens (Human)
-
標記方式:Non-conjugated
本頁面中的產品,HIST2H2AC Antibody (CSB-PA010445LA01HU),的標記方式是Non-conjugated。對于HIST2H2AC Antibody,我們還提供其他標記。見下表:
-
克隆類型:Polyclonal
-
抗體亞型:IgG
-
純化方式:>95%, Protein G purified
-
濃度:It differs from different batches. Please contact us to confirm it.
-
保存緩沖液:Preservative: 0.03% Proclin 300
Constituents: 50% Glycerol, 0.01M PBS, PH 7.4 -
產品提供形式:Liquid
-
應用范圍:ELISA, IHC
-
推薦稀釋比:
Application Recommended Dilution IHC 1:20-1:200 -
Protocols:
-
儲存條件:Upon receipt, store at -20°C or -80°C. Avoid repeated freeze.
-
貨期:Basically, we can dispatch the products out in 1-3 working days after receiving your orders. Delivery time maybe differs from different purchasing way or location, please kindly consult your local distributors for specific delivery time.
-
用途:For Research Use Only. Not for use in diagnostic or therapeutic procedures.
相關產品
靶點詳情
-
功能:Core component of nucleosome. Nucleosomes wrap and compact DNA into chromatin, limiting DNA accessibility to the cellular machineries which require DNA as a template. Histones thereby play a central role in transcription regulation, DNA repair, DNA replication and chromosomal stability. DNA accessibility is regulated via a complex set of post-translational modifications of histones, also called histone code, and nucleosome remodeling.
-
基因功能參考文獻:
- we found an excess of mutations in genes encoding histone H2A and H2B, as well as significant amplification of the segment of chromosome 6p harboring the histone gene cluster containing these genes.We also found frequent deletions of the genes TP53 and MBD3 (a member with CHD4 of the nucleosome remodeling deacetylase complex). PMID: 27791010
- Glycated-H2A histone is better bound by serum anti-DNA autoantibodies in systemic lupus erythematosus patients, and could be a likely trigger for the disease. PMID: 25065453
- Our results provide mechanistic insight into how post-translational modification of H2A at the site of a photolesion initiates the repair process and directly affects the stability of the human genome. PMID: 22334663
- Aurora-B-dependent phosphorylation of condensin promotes its association with histone H2A and H2A.Z, which we identify as conserved chromatin 'receptors' of condensin PMID: 21633354
- L3MBTL2-specific RNAi resulted in increased expression of target genes that exhibited a significant reduction in H2A lysine 119 monoubiquitination. PMID: 21596310
- AT1R modify the composition of histone H2A and post-translational modifications. PMID: 20838438
- deiminated residues were present in H2A (1-56) and H4 (1-52) PMID: 15823041
- Monoubiquitinated histone H2A in native chromatin coimmunoprecipitates with the endogenous DDB1-CUL4A(DDB2) complex in response to UV irradiation. PMID: 16473935
- The 2 MDa GCN5 HAT-containing metazoan TFTC/STAGA complexes contain a histone H2A and H2B deubiquitinase activity. PMID: 18206972
- DDB1-CUL4B(DDB2) is more efficient than DDB1-CUL4A(DDB2) in monoubiquitinating histone H2A in vitro. PMID: 18593899
- The change in nucleosome core particle conformation induced by global histone acetylation is dependent on H2A/H2A.Z acetylation. PMID: 19385636
- Study demonstrated that RNF168 is endowed with ubiquitin ligase activity both in vitro and in vivo, which targets histones H2A and H2AX, but not H2B, forming K63 polyubiquitin chains. PMID: 19500350
- Results demonstrate the potential of C-terminal truncated H2A to contribute to the process of carcinogenesis through epigenetic mechanisms. PMID: 19667409
顯示更多
收起更多
-
亞細胞定位:Nucleus. Chromosome.
-
蛋白家族:Histone H2A family
-
數據庫鏈接:
Most popular with customers
-
YWHAB Recombinant Monoclonal Antibody
Applications: ELISA, WB, IHC, IF, FC
Species Reactivity: Human, Mouse, Rat
-
Phospho-YAP1 (S127) Recombinant Monoclonal Antibody
Applications: ELISA, WB, IHC
Species Reactivity: Human
-
-
-
-
-
-